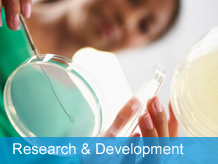
1

Innovation
The center now has more than 400 employees,
including one academician of the CAE Member, 11 experts enjoying
special government allowances, 94 senior technicians, and more than
60% of the professional technicians. In the national "Seventh Five
Year Plan", "Eighth Five Year Plan", "Ninth Five Year Plan",
"Fifteenth Five Year Plan", "Eleventh Five Year Plan", "Twelfth Five
Year Plan", "Thirteenth Five Year Plan", "Fourteenth Five Year
Plan", "973" Plan, "863" Plan, National Science and Technology
Research and Development Program...
The center is the earliest enterprise in
China to achieve automated production of reverse osmosis and
nanofiltration membrane products. After more than 40 years of
technological research and development, we have independently
developed four categories of water treatment membrane materials and
products: reverse osmosis, nanofiltration, hollow fiber
ultrafiltration, and MBR. Currently, we have 16 series and more than
40 product models......
After years of research and engineering
application in the field of liquid separation membranes, the center
has achieved a series of engineering technological achievements. Its
radiation and diffusion in industries such as seawater desalination,
high-performance liquid separation membrane materials......
| Contact Us | Site Map | Legal | Links | RSS Hangzhou Water Treatment Technology Development Center Co., Ltd. all rights reserved.Without written authorization from China National BlueStar (Group) Co.Ltd. such content shall not be republished or used in any form. |